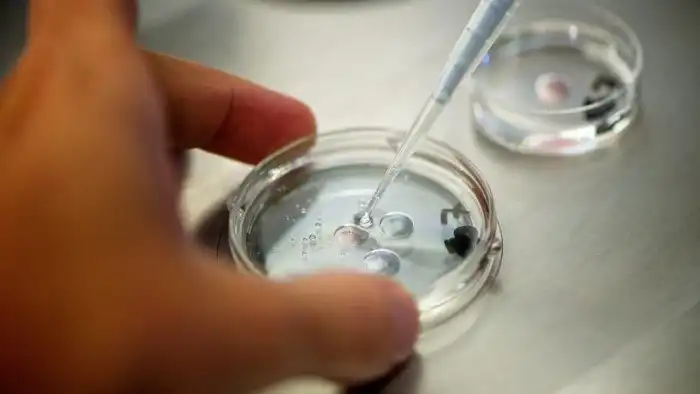

10 вещей, которые понадобятся людям чтобы успешно колонизировать космос
Многие ученые уверены, что рано или поздно человечество колонизирует космос. Некоторые даже считают это неизбежным — если, конечно, человек не вымрет и его место не займут крысы или муравьи. Чтобы успешно расселиться по Вселенной, надо сперва стать киборгами, создать армию роботов, генетически модифицироваться и научатся скидывать информацию не на флешку, а на бактерию. Рассказываем, что потребуется для освоения космоса.
1. Космический корабль
Чтобы начать колонизацию космоса, нужно на чем-то отправиться в путь. Увы, это не так просто, как расселиться по своей планете. Предполагается, что ближайшая от Земли планета, пригодная для обитания, находится на расстоянии 14 световых лет, т. е. более чем в 131 триллионе км от нас. Далековато, согласитесь. Но если мы освоим такие длинные космические перелеты, и вопрос об отправлении первой колонии людей будет решен, то сколько человек должно вмещать космическое судно? Сколько смельчаков должны отправиться в первый межгалактический полет?
Например, проект MarsOne планирует в 2026 году делегировать 100 человек, чтобы начать колонизацию Марса. Но Марс — наш сосед, а путешествия в другие галактики длятся по 150 лет и требуют другого количества людей. Антрополог Портландского университета Кэмерон Смит утверждает, что необходимо отправить по крайней мере 20 тысяч человек, а в идеале все 40, чтобы заселиться на новой планете. Естественно, что из этих 40-а тысяч как минимум 23 тысячи должны быть репродуктивного возраста. Куда так много? Для генетического разнообразия и на случай возможной катастрофы, если такая вдруг уничтожит часть популяции. Ну, и чтобы не было скучно.
2. Киборги
Термин «киборг» появился в 1960 году — его ввели ученые Манфред Клайнс и Натан Клин, размышляя над возможностями выживания человека вне Земли. Идея заключается в том, чтобы «добавлять» в биологический организм (т. е. в нас) механические и электронные компоненты. Предполагалось, что это повысит шансы человека выжить во внеземных условиях.
Эту мысль развил (возможно, до крайности) эксперт по кибернетике Университета Ридинга (Великобритания) Кевин Уорвик. Он предлагает оставить от человека один лишь головной мозг, пересадив его в тело андроида. Это, по словам ученого, будет способствовать колонизации космоса.
3. Искусственный интеллект
Как вообще может идти речь о колонизации других галактик, если мы все еще не можем освоить соседние планеты? Этим вопросом задаются ученые: да, они ставят под сомнения интеллектуальные способности человека. Но если задача непосильна для человека, возможно, с ней справится искусственный интеллект.
Есть два основных условия, при которых искусственный интеллект действительно может помочь человеку в освоении космического пространства. Во-первых, искусственный интеллект должен быть умнее нас. Настолько умнее, чтобы раскрыть секреты межгалактических странствий, тайны кротовых нор и другие загадки Вселенной. При этом, конечно, он не должен убить человека (пока не поможет колонизировать космос).
Во-вторых, мы могли бы разработать не просто компьютер, а разумных существ, которые бы проложили для нас путь сквозь звезды. Запрограммировать искусственный разум таким образом, чтобы он был направлен на поиск пригодных для жизни планет, а затем строил бы межгалактический автобан для людей. И тогда нам оставалось бы просто загрузить космический корабль всем необходимым.
4. Генетически сконструированные эмбрионы
Космические путешествия для человека чреваты страшными последствиями для здоровья. Дорога до ближайшего Марса, которая занимает всего лишь от 18-и до 30-и месяцев, — это высокий риск развития рака, деградации тканей, потери плотности костной ткани, повреждения головного мозга. Есть мнение, что колонизация новой планеты возможна только генетически модифицированными людьми.
Если модифицировать эмбрионы и отправить на другую планету, там их можно будет вырастить или даже распечатать с помощью биологического 3D-принтера. В этом может помочь искусственный интеллект, который уже «освоился» на новой территории. Транспортировать эмбрионы гораздо проще, чем придумывать, как отправить людей в путешествие длиной в сотни лет.
5. Генетически модифицированные люди
Краеугольный камень межгалактических путешествий — вопрос транспортировки людей. В NASA разрабатывают технологию глубокой гибернации, т. е. введение человека в состояние спячки.
Однако гибернация — не анабиоз и не спасает от старения, хотя и замедляет процесс. Да, человек может проспать всю жизнь на космическом корабле, но это не сильно поможет колонизации космоса. Поэтому решение за генетикой — сделать так, чтобы земляне не старели. Ну, или старели так медленно, чтобы продолжительность жизни составляла тысячу лет.
Если мы продлим себе жизнь с помощью генетики, то не будет необходимости спать во время космического перелета: можно будет работать в ходе путешествия. Когда (и если) такое станет реальным, было бы хорошо, чтобы генетика избавила человека от одиночества и скуки. Это пригодится пилоту космического корабля, которому надо сотни лет одному управлять судном и при этом не сойти с ума.
6. Эволюция
Существует теория, согласно которой человек может эволюционировать так, что в итоге будет способен перемещаться в космическом пространстве. Например, у первого поколения людей на Марсе начнутся ощутимые изменения в теле, а их дети появятся на марсианский свет уже с этими изменениями. В итоге всего через несколько поколений люди на Марсе станут одним из подвидов человека.
Аргумент в пользу этой теории — исследование расселения людей по Земле. Каждый раз, заходя на новые территории, человек обретал какие-то дополнительные физические качества, что делало человечество более разнообразным. При переселении на другую планету нам придется столкнуться с совершенно чуждыми явлениями — и перемены будут гораздо сильнее, чем при смене земного континента. Эволюционируя в этом направлении, человек станет все более и более приспособленным для межгалактических перелетов.
7. Самовоспроизводящийся зонд
В 1940-е годы венгерский математик Джон фон Нейман разработал теорию самовоспроизводящихся роботов. Задумка такова: маленькие роботы производятся в геометрической прогрессии. Двое роботов производят четырех, четверо роботов — шестнадцать, и т. д. В итоге миллионы этих роботов составят своего рода зонд, который будет достигать всех четырех «углов» Млечного Пути.
Физик Митио Каку называет такой способ «математически наиболее эффективным» для изучения пространства. Сперва роботы найдут безжизненные спутники, затем создадут там заводы по производству таких же роботов, потом начнут использовать природные месторождения.
8. Сфера Дайсона
Сфера Дайсона — гипотетический астроинженерный проект — возможно, приближает нас к перспективам построить что-то вроде Звезды Смерти. Фримен Дайсон предположил, что развитая цивилизация должна применять такое сооружение для максимально возможного использования энергии центральной звезды. В ходе процесса будет производиться большое количество инфракрасного излучения. Таким образом, поиск внеземных цивилизаций Дайсон предложил начать с обнаружения мощных источников инфракрасного излучения.
Идея сферы Дайсона — это прежде всего гипотеза для поиска других разумных цивилизаций. А некоторые ученые считают, что мы сами могли бы создать аналогичную сферу (допустим, с помощью самовоспроизводящихся роботов), и, собирая и используя энергию окружающих звезд, начать колонизацию космоса.
9. Терраформирование
Изменение условий жизни на планете. Одна из существенных проблем заселения других планет заключается в их непригодности для жизни людей. Например, Марс для нас слишком сухой и слишком холодный. Ученые полагают, что эти условия можно изменить.
Так, необходимо вывести микроорганизмы, которые бы потребляли локальные природные ресурсы. Это изменит почву (станет возможным выращивать растения), появится больше кислорода. Кроме того, микроорганизмы откачивали бы газ из воздуха. Благодаря всему этому толщина атмосферы Марса увеличится: и тогда планета станет теплее, и на ней может возникнуть вода. Микробиолог Гэри Кинг из Университета Луизианы полагает, что терраформирование Марса начнется в течение ближайших двух столетий.
10. Бактерии
ДНК — самая известная система хранения данных: там «записана» сложнейшая информация. Геном человека (весь наш наследственный материал) занимает около 750 мегабайт. А несколько лет назад исследователи из Гарварда «закачали» в один грамм ДНК 700 терабайт данных.
А еще ДНК невероятно прочна. Она может выжить при температуре до тысячи градусов, а может быть криогенно заморожена. Наконец, ДНК универсальна.
Ученые предполагают, что в течение 20-и лет мы научимся хранить данные ДНК человека в бактериях. Тогда можно будет посылать бактерии на другие планеты вместе с микробами (которые займутся терраформированием). Основная сложность — запрограммировать бактерию на конкретные действия на новой планете: ведь она должна знать, что делать, когда прибудет на место. Возможно, как только решится этот вопрос, на новых планетах люди будут развиваться из бактерий.